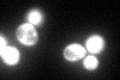
YBR218C
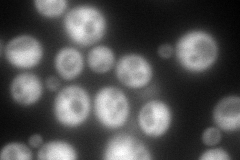
YBR218C
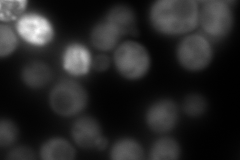
YBR218C
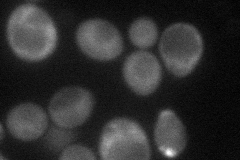
YBR218C
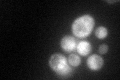
YBR218C

View description
Pyruvate carboxylase isoform, cytoplasmic enzyme that converts pyruvate to oxaloacetate; highly similar to isoform Pyc1p but differentially regulated; mutations in the human homolog are associated with lactic acidosis
Localization:
Intensity:
Fold change:
Significance:
-
C’ GFP library in SD
cytosol151.36 -
N' NOP1pr-GFP in SD
cytosol288.347 -
N' TEF2pr-mCherry in SD
cytosol23.5401 -
N' NATIVEpr-GFP in SD

cytosol96.0727 -
N' TEF2pr-VC and Cyto-VN in SD
cytosol62.0346 -
C’ GFP library in SD+DTT

cytosol111.80.73No -
C’ GFP library in SD+H2O2

cytosol168.421.11No -
C’ GFP library in Starvation Media
cytosol127.670.84No -
C’ GFP library on the background of Pup2-DaMP

cytosol -
C’ GFP library on the background of CCT mutant

cytosol177.0521.16967No
